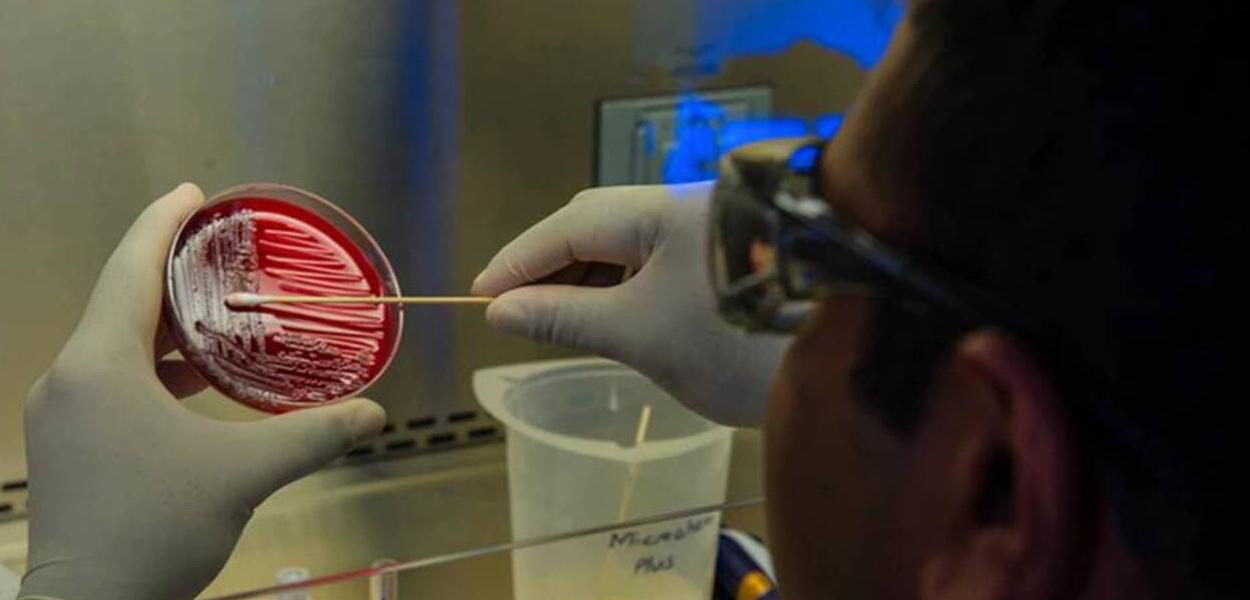

EUA identificam primeiro caso de Covid-19 provocado pela ômicron, nova variante do coronavírus
Primeiro caso da nova cepa em território estadunidense foi identificado em São Francisco, na Califórnia, em uma pessoa que retornou ao país em um voo originário da África do Sul, no último dia 22
✅ Receba as notícias do Brasil 247 e da TV 247 no canal do Brasil 247 e na comunidade 247 no WhatsApp.
247 - O Centro de Controle e Prevenção de Doenças (CDC) dos Estados Unidos confirmaram, nesta quarta-feira (1), o registro do primeiro caso de Covid-19 relacionado à variante ômicron do coronavírus. O primeiro caso da nova cepa em território estadunidense foi identificado em São Francisco, na Califórnia, em uma pessoa que retornou ao país em um voo originário da África do Sul, no último dia 22.
De acordo com o G1, a variante ômicron já foi identificada em ao menos 24 países. O Brasil registra três casos de Covid-19 ligados à nova cepa do coronavírus. Além dos EUA, há casos confirmados desta mutação - identificada pela primeira vez na África do Sul -, em ao menos outras 24 nações.
De acordo com a Organização Mundial da Saúde (OMS, a ômicron é uma variante “de preocupação” em função do grande número de mutações identificadas. Na terça-feira (30), as autoridades de saúde holandesas afirmaram que a variante - identificada há pouco mais de uma semana na África do Sul uma semana antes do que se acreditava.
Assine o 247, apoie por Pix, inscreva-se na TV 247, no canal Cortes 247 e assista:
Assine o 247, apoie por Pix, inscreva-se na TV 247, no canal Cortes 247 e assista:
Comentários
Os comentários aqui postados expressam a opinião dos seus autores, responsáveis por seu teor, e não do 247